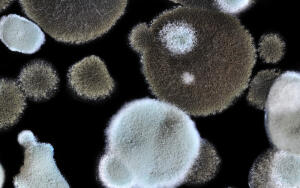

Красота и здоровье → Что такое черная плесень и чем она опасна для людей, перенесших Covid-19?
Пандемия научила относиться к беде жителей другого конца Земли, как с собственной. Пугающие новости из Индии не кажутся экзотическим триллером — грибок, поражающий людей в этой стране, обитает и в наших
Карл-Август Аванти 0



Игорь Вадимов, да, Вы правы - речь шла именно о кори. Если обратиться к самым свежим публикациям врачей из США, то ситуация там...